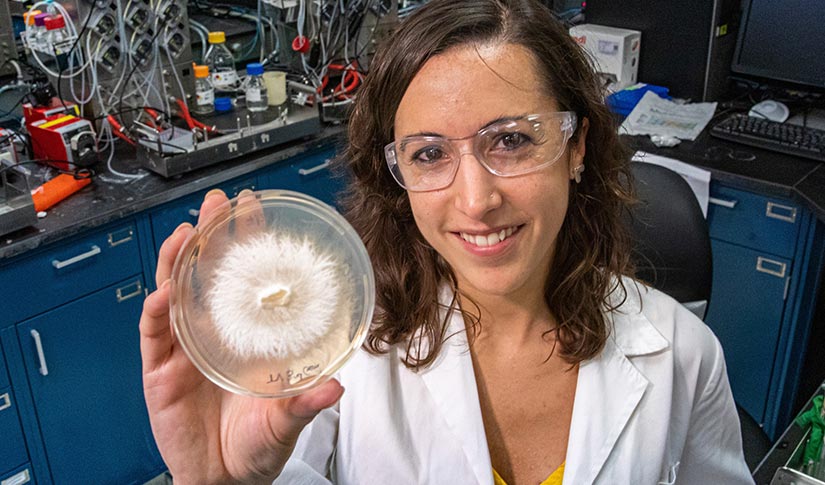
A woman holding up a research sample.

NREL Caps Off a Year of Accomplishments With National Bioenergy Day
Organizations Nationwide Celebrate Breakthroughs in Producing Energy and Goods From Sustainable Resources

Last year, NREL researchers expanded research into the use of biomass for sustainable marine and aviation fuel, as well as for production of plastic products. Photos courtesy of iStock
On Oct. 20, the U.S. Department of Energy's (DOE's) National Renewable Energy Laboratory (NREL) will join organizations and individuals nationwide in celebrating the ninth annual Bioenergy Day. The day commemorates advancements in the use of biomass to produce energy from sustainable resources such as farm, forestry, and other plant waste.
This year, NREL is also taking this opportunity to showcase recent breakthroughs in the conversion of biomass using more eco-friendly processes and to manufacture products that are less carbon-intensive, are easier to recycle, and can readily be used to create new high-quality goods.
Bioenergy is a critical component in the nation's strategy to reverse climate change, while shifting reliance to domestic energy resources and growing the U.S. economy. Research by NREL and other national laboratories funded by DOE's Bioenergy Technologies Office (BETO) has revealed potential to produce 1 billion dry tons of biomass a year, without any negative effect on U.S. food or livestock feed provisions. Biomass could displace as much as 25% of U.S. petroleum consumption.
Bioenergy already supplies about 5% of the nation's total energy. More than 50% of bioenergy is used to generate heat and electricity for industrial operations, with biofuels for transportation consuming another 28%. Smaller amounts of bioenergy provide heat and electricity for residential and non-industrial commercial operations.
In addition, NREL researchers are exploring ways to create commodities and new products using some of the same feedstocks, infrastructure, and technologies originally developed for biofuels. This makes it possible to replace single-use plastics that are typically petroleum-based with bio-based materials that can be recycled and used to manufacture new and better products, a process known as upcycling. Upcycling is an important strategy in establishing a circular economy to extend materials' lifespan, while reducing waste, conserving resources, and boosting efficiency.
In the last 10 years, DOE research and development (R&D) has reduced the cost of biofuel production by close to 50%. It is estimated that bio-based activities generate more than $48 billion in revenue for U.S. businesses, supporting more than 285,000 jobs in multiple sectors.
The following briefs highlight NREL research accomplishments from the last year in the areas of bioenergy and bio-based products and processes.
Bioenergy R&D Highlights
Leftovers Help Clear Aviation Industry for Net-Zero Takeoff
With jet fuel demand set to double in the coming decades, fuel and engine innovations will be critical to meeting the nation's ambitious net-zero-emissions goals. A novel biorefining process developed by NREL and its partners uses food waste and other wet wastes to produce drop-in sustainable aviation fuel. The resulting blend is estimated to have a carbon footprint 165% smaller than that of conventional fossil-based jet fuel.
Read more about how this research could help reductions in jet emissions take off.
Integrated Bioenergy-Hydrogen Systems Produce Low-Emission Fuels at Lower Costs

Wind and solar energy, as well as battery energy storage, will all be vital components in tomorrow's clean electricity systems—but making the leap to a truly sustainable energy system will also rely on low-carbon fuels. NREL is validating utility-scale processes to integrate hydrogen-producing electrolyzers with biomethanation reactors to produce renewable natural gas, sustainable aviation fuel, and more. These new approaches eliminate expensive equipment and steps to potentially reduce system electrolyzer costs by 5%–10%, nearly double fuel yield, and make it possible to blend hydrogen in existing natural gas pipelines.
Read more about how these systems can work together to deliver low-carbon fuels.
Biofuels Buoy Marine Operations' Environmental Compliance Efforts
Aggressive targets have been set by global shipping organizations to reduce vessels' sulfur and greenhouse gas (GHG) emissions. Fuel costs already make up more than 50% of ship operating expenses. Equipment and fuel options currently available to meet these new regulations involve steep additional costs. NREL and its research partners discovered that marine fuels produced entirely from biomass can reduce life cycle GHG emissions by 67%–93% in comparison to the standard heavy fuel oil and lower cost barriers associated with compliance.
Read more about how this research could help the marine industry meet stringent new environmental regulations.
Biorefining Process Combines Electrochemistry With Fermentation To Boost Fuel Yields and Cut GHGs
Processes that make renewable diesel and sustainable aviation fuel from biomass can lose as much as one-third of the carbon during fermentation. This not only lowers fuel yields, but it also accelerates climate change by releasing carbon dioxide (CO2) into the atmosphere. Thanks to a nearly $3 million award from the DOE's Advanced Research Projects Agency-Energy (ARPA-E), an NREL-led project will combine electrochemistry with fermentation to produce biofuels without emitting any GHGs.
Read more about how NREL and its partners are making biofuel production cleaner and more efficient.
Enzymatic Process Common in Plants and Bacteria Conserves Energy

Some organisms such as bacteria and plants rely on electron bifurcation—a complicated enzymatic process—to conserve energy. Bifurcation actually creates a product that has more energy than the material from which it was derived. An NREL chemist and her research partners were recognized with an award from the National Academy of Sciences for their work in this area. Ultimately, researchers hope to design an artificial electron bifurcation system that can help produce biofuels or reduce the amount of CO2 released in industrial activity.
Read more about this scientific discovery and its possible implications for biofuels development.
Fungus Contributes Potential New Strategies for Lignin-Based Biofuels and Carbon Sequestration
Found in plants such as switchgrass and trees, lignin is an energy-dense organic polymer with enormous potential as a feedstock for biofuels. It also has been called "the most recalcitrant biopolymer on Earth." The difficulty involved in deconstructing lignin and converting it into compounds needed to make biofuels has presented significant challenges. For the first time, NREL scientists have shown that white-rot fungi use digested lignin as a carbon source. These findings present possible new strategies for carbon sequestration and development of bio-based fuels and products.
Read more about this foundational research with potential to unlock a crucial source of biomass.
Sugar Content Sweetens Value of Small Trees as Feedstock for Biofuels
Biomass growers typically try to plant as many tall, fast-growing trees as possible per acre. Until now, little consideration has been given to the quantity or quality of fuel those trees will yield. Research by NREL and its partners reveals that the economic importance of tree sugar content equals that of tree size. The techno-economic study explains how sugar content can boost the value of smaller trees in regions less suited to cultivating larger species.
Read more about how tree composition can effect feedstock quality and biorefinery economics.
Bio-Based Processes and Products R&D Highlights
Tandem Use of Enzymes Speeds Up Plastic Digestion

Every year, 82 million metric tons of PET plastic is turned into single-use beverage bottles, textiles, and food packaging. Most of this difficult-to-recycle plastic ends up in landfills. NREL and its partners in the Bio-Optimized Technologies to keep Thermoplastics out of Landfills and the Environment (BOTTLE) Consortium have discovered that two synergistic enzymes can be used together to effectively to break down polyethylene terephthalate (PET). The tandem use of two plastic-eating enzymes can more quickly break down the PET material found in beverage bottles, clothing, and carpeting. Researchers hope similar processes will eventually make it commercially viable to recycle the tons of PET plastic discarded each year.
Read more about the promise this new method holds for improving the rate of plastic recycling.
New Analysis Shows That Enzyme-Based Plastics Recycling Is More Energy-Efficient and Better for Environment
NREL is leading researchers in the BOTTLE Consortium in addressing the many challenges inherent in plastic recyclability. Recent analysis shows that enzyme-recycled PET has potential improvement over conventional, fossil-based methods of PET production across a broad spectrum of energy, carbon, and socioeconomic impacts. It is estimated that enzymatic recycling processes can reduce total energy used in the plastic production supply chain by 69%–83% and related GHG emissions by 17%–43%. This model could be scaled up and lead to new opportunities for PET recycling, including a mechanism for recycling textiles and other materials made from PET that are traditionally not recycled today.
Read more about this energy-efficient approach to diverting plastics from the waste stream.
Supply-Chain Data Provides Sustainability Benchmarks for Plastics Recycling and Redesign

Plastics production accounts for about 11% of all U.S. manufacturing energy consumption. At the same time, the United States generates the largest share of waste plastics in the world. Researchers in the BOTTLE Consortium are developing renewable plastics and exploring new processes for plastic recycling and upcycling. Data calculated and compiled at the supply-chain level will make it possible to benchmark proposed innovations against the energy consumption and GHG emissions related to current manufacturing practices.
Read more about the data and tools that are helping steer this initiative.
Learn More
Pause to celebrate Bioenergy Day Oct. 20, and learn more about NREL's circular economy research and the NREL-led BOTTLE Consortium.
Last Updated Jan. 22, 2026